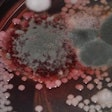
Rock River Laboratory Tmr Hygiene Diagnostic Package

The Rock River Laboratory TMR Hygiene Diagnostic package offers nutritionists a quick and accurate means to identify the root of significant health issues, including sick animals, reduced production performance and, in some cases, even death, and aptly counter with necessary management and feed changes to eliminate the issues at hand. Quickly identifying the challenges at hand is key to combatting health-compromising feed components. The TMR Hygiene Diagnosis package includes: mold, yeast, and vomitoxin (DON) count; mold identification, Clostridium perfringens (C. perfringens) and other enterobacteria count; TMR nutrient analysis; and wet chemistry rumen starch digestion analysis.